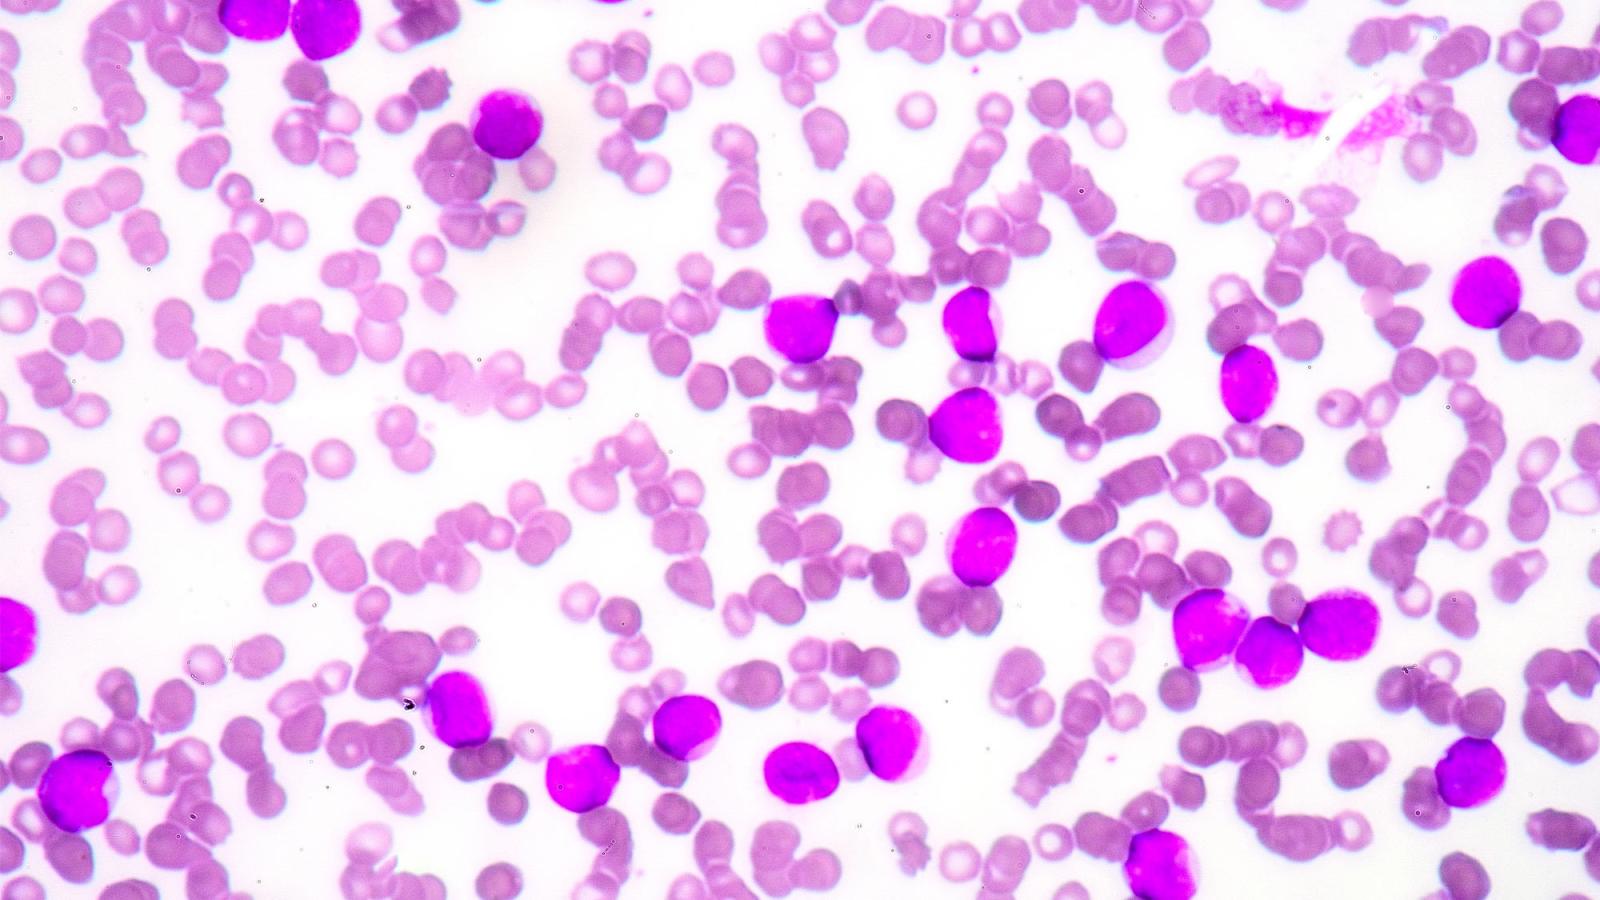

From Hospital Bed to Research Lab: Drew D’Auteuil’s Inspiring Story
As a child, a rare blood condition changed Pace alumnus Drew D’Auteuil ’21’s life forever. Now, armed with a Pace education, he’s using the lessons of that experience to serve others.
In June 2009, as the end of fourth grade approached and the days warmed with summer’s arrival, ten-year-old Drew D’Auteuil was preparing for the next chapter of his typical Amherst, New Hampshire, childhood. He was a standout student with many friends, an avid soccer player and talented gymnast, a dog lover, a Nickelodeon watcher, and the third child of three.
Another school year was ending, another year passing in what had been a happy, healthy adolescence. But over the next several months, a series of debilitating medical challenges, rare diagnoses, prolonged hospitalizations, and miraculous recoveries would upend Drew’s typical childhood and change his life forever, setting him on a path that would lead him through Pace University’s Biology Department and into a research position at the same hospital where he had received pediatric treatment.
It started with shortness of breath, skin rashes, and the odd bruise after gymnastics practice. “Being young, I didn’t think much of it,” Drew said. “You don’t take those things seriously at that age.”
When his mother, an attentive nurse practitioner, noticed the severity and persistence of his symptoms, she brought him in for blood work. The results were immediately alarming, and Drew was rushed to the hospital for further evaluation.
It wasn’t long before Drew and his family received the diagnosis: aplastic anemia, an extremely rare blood condition resulting from damage to the bone marrow.

“Basically, your bone marrow ceases to produce the blood cells your body needs,” Drew said. “Even today, we don’t really know what caused it. It could have been a fluke, maybe a virus. Who knows? But my bone marrow stopped producing enough white blood cells, red blood cells, and platelets.”
Drew and his family spent those first weeks of summer vacation adapting to the new normal of his condition and working with doctors to devise a way forward. The first treatment option involved specialized chemotherapy designed to clear the damaged bone marrow and revitalize blood cell generation. When that failed to produce the desired results, a full bone marrow transplant was scheduled for the fall.
The date was set, a donor was identified, and just weeks after his eleventh birthday, Drew received his transplant. The procedure was a success, and the next 100 days—a crucial period for transplant patients during which the risk of significant side effects is at its highest—elapsed with no sign of major complications. The new bone marrow was doing its job, and while Drew would never fully return to the typical childhood that had been so suddenly disrupted, it seemed that the worst was finally behind him.
But then, just a few months later, he started to develop a cough. “It just wouldn’t go away,” Drew said. “And then I started feeling tired.”
He was taken to the emergency room, where doctors discovered that his oxygen levels were plummeting fast.
“The next thing I remember was waking up and not being able to move,” Drew said. “Then my parents told me I had been in a medically induced coma for a week.”
It was definitely a full circle moment for me.
Drew had suffered from acute respiratory distress syndrome, an often-fatal condition in which the body is deprived of essential oxygen due to fluid in the lungs’ air sacs, likely resulting from the immunocompromising effects of his aplastic anemia treatment. That critical oxygen depletion led to multi-organ failure. His condition quickly turned grave, and his family began to prepare for the worst. Visitors came to the hospital for what they feared might be their final goodbyes. Last rites were given.
And then, one week after arriving at the hospital, he woke up. He didn’t know where he was, he didn’t know what he had experienced, he could not move his neck without extreme difficulty, but he had survived.
“It can be traumatic to think about,” Drew said. “For someone like me, a bone marrow transplant patient, an immunocompromised person, to go through something like that—the prognosis is basically in the negatives. But thankfully, I got through it. It was kind of miraculous.”
Recovery was arduous. The next year was spent relearning to walk, and more than five years of intensive physical therapy were required to regain the majority of his strength. But the unfaltering support of his family and his own inexhaustible perseverance continued to carry him through.
“My own memory is a little hazy, but my parents and my doctors always tell me that I rarely, if ever, complained,” he said. “I guess I realized that this was my new normal. This is how it was going to be, and I was going to roll with it.”
When high school was ending, Drew knew that he wanted to attend college in the big city, and he knew that—inspired by his mother’s success as a nurse practitioner and by his own history of health challenges—he wanted to pursue a career in the medical field. When Pace recognized his record of high achievement with a generous scholarship package, the decision of where to enroll was an easy one.
“It was a great community and great sense of camaraderie in Pace’s Biology Department,” Drew said. “It was very easy to get to know my classmates, and I was able to make connections with almost all the students in my program. My time at Pace cemented for me that, yes, I definitely want to be in a STEM-related field.”

In 2021, Drew graduated from Pace magna cum laude with a degree in biology and a determination to build vital medical research experience. He immediately began submitting applications to major hospitals in his native New England, including the Dana-Farber Cancer Institute in Boston, which had played a crucial role in his own treatment as a child.
After emailing the principal investigator of a Dana-Farber neuro-oncology lab about a vacant position, Drew secured a role as a research technician helping to explore novel treatments for brain tumors.
Just over a decade after Drew first began visiting Dana-Farber as a patient, he was now a member of the Dana-Farber team, contributing to groundbreaking research with the potential to change lives.
“It was definitely a full circle moment for me,” Drew said.
Today, while lingering side effects often remind Drew of the health crises that turned his typical New Hampshire childhood upside down, he is driven to use the lessons of those memories and the education he received at Pace in service of those who, like him, have been forced to navigate life-altering illness.
“I think I bring to the table an empathetic approach,” he said. “I know on a very personal level what patients are going through. It’s beyond studying something in a textbook. I’ve dealt with these things myself.”
More from Pace Magazine
From campus renovations to pioneering research, the Summer 2024 edition of Pace Magazine captures the vibrant spirit and accomplishments of our community. We are proud to share stories of our top-ranked Environmental Law program, new faculty members, and much more.
Why do humans speak the way they do? College of Health Professions Associate Professor Sethu Karthikeyan, PhD, is exploring the evolutionary biology behind voice pitch.
Lubin’s Ivan Fox Scholar and Professor of Law Jessica Magaldi, JD, is helping to close the gap between what’s reflected in course material and reality, by examining representation of women as protagonists and antagonists in case studies.